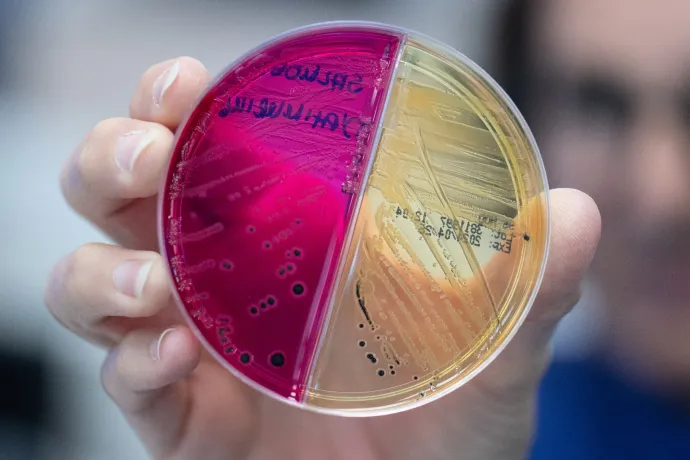

Semmit nem érnek a drágán árult mikrobiomtesztek, mert még azt se tudjuk, milyen az egészséges mikrobiom
Az utóbbi években óriási egészségügyi trend lett a mikrobiomot tartani minden bajunk forrásának és egyben a megoldásának is : önjelölt és valós szakértők állítják, hogy a bél mikrobiomjában az egyensúly felborulása a felelős egy sor betegségért, és hogy ennek helyrehozásával a problémák gyógyíthatók, vagy legalábbis enyhíthetők. A gond ezzel csak az, hogy jelenleg a tudománynak még csak elég halvány képe van arról, hogyan is néz ki pontosan egy egészséges mikrobiom, és milyen az, amikor felborul. Ez abból az egyszerű tényből fakad, hogy minden ember mikroorganizmus-közössége egyedi, és emiatt nem igazán lehet sztenderdeket felállítani arra, hogy milyen az, amikor jó, és milyen az, amikor rossz.
Az első számú hazai mikrobiompápa Schwab Richárd belgyógyász, gasztroenterológus és kutatóorvos, ő gyakorlatilag a mikrobiom Máté Gábora: azt állítja, hogy a felborult bélflóra egy sor súlyos betegség okozója, önmagában is lehet kiváltó oka például egy daganatnak, és az összetétele számos kóros állapotért, például a demenciáért és az érelmeszesedésért is felelős. A Telexnek adott interjújában azt mondta, hogy a betegségek kialakulásában 95 százalék a környezeti tényező, és csak 5 százalék a genetika, illetve hogy a betegségeink 50-60 százaléka közvetlenül a táplálkozásba van kódolva.
Ez elég durván leegyszerűsítő megközelítés: egy, a Nature szaklapban megjelent tanulmány kimutatta például, hogy a mikrobiommal összefüggésben gyakran emlegetett 2-es típusú cukorbetegség 28,4 százalékban öröklődő, a szintén a mikrobiommal sűrűn kapcsolatba hozott elhízás pedig 46,3 százalékban a géneken múlik. Persze a génjeinken kívül a mikrobiomunk egy részét is örököljük, de ezek a számok így is cáfolják, hogy a környezeti hatásoknak annyira extrém nagy szerepük lenne. És hogy mik az igazán súlyos környezeti hatások? Az Egyesült Államok Betegségmegelőzési és Járványügyi Központja és az Egészségügyi Világszervezet szerint a nem fertőző betegségek jelentős része megelőzhető lenne a dohányzás, a fizikai inaktivitás, az alkoholfogyasztás és az egészségtelen étrend visszaszorításával.
Ami a mikrobiom okozta betegségeket illeti, az Amerikai Tudományos és Egészségtanács azt írja: bár a mikrobiom összetételének jelentős megváltozása valóban negatív hatásokat válthat ki, és betegségek felgyorsulásához is hozzájárulhat, a jelenlegi kutatások csupán összefüggést mutatnak ki a kettő között, azt nem bizonyítják egyértelműen, hogy ezek az elváltozások okozzák-e a betegségeket, vagy éppen azok következményeként alakulnak ki. A legtöbb, betegséggel és mikrobiommal kapcsolatos kutatás a bélmikrobióta (köznyelvi elnevezéssel bélflóra) egészségét és az abban található mikrobák meglétét és hiányát biomarkerként kezeli, vagyis azt mondja, hogy ez egy betegség jelenlétét vagy annak lefolyását jelzi – és nem azt, hogy a betegség kialakulását okozza.
A mikrobiomot ezzel együtt is nagyon komolyan kell venni, hiszen olyan fontos rendszer a szervezetben, hogy egyes kutatók már külön szervként kezelik. 150-szer több gén található a bélmikrobiomban, mint a humán genomban, és annyi mikrobából áll, ami nagyjából két kilogrammot tesz ki a testtömegünkből.
A bélflóra rendkívül fontos szerepet játszik az egészségünkben, az elfogyasztott táplálékból olyan vegyületeket állít elő, amik az egész szervezetünkre jótékony hatással vannak. De a bélrendszerünkben élő mikrobák különféle vitaminokat is termelnek, olyan hormonokat szintetizálnak, mint például a szerotonin – ami befolyásolja az anyagcserénket és a hangulatunkat –, valamint fermentálják a rostokat, amikből gyulladáscsökkentő hatású, rövid szénláncú zsírsavak keletkeznek. Az tehát, hogy a mikrobiom egészsége nagyon fontos, tény. Csakhogy:
Nem tudjuk, kinek milyen az „egészséges mikrobiom”
„A bélflórát rengeteg különböző apró élőlény szimbiózisa, együttműködése, együttélése alkotja – mondta a Telexnek dr. Molnár Tamás, a Szegedi Tudományegyetem gasztroenterológiai tanszékének vezetője. – Ha erről beszélünk, általában mindenki a baktériumokra gondol, de a bélflórát a vírusok, gombák és különböző egysejtűek is alkotják. A bélflóra számos funkciót lát el, rengeteg metabolitnak nevezett anyagot termel. Ezek a metabolitok lehetnek vitaminok, emésztőenzimek, különböző olyan anyagok, amelyek bizonyos szervek, vagy például az immunrendszer működéséhez szükségesek. Ezáltal nemcsak a bélben, hanem más szervekben is fontos élettani szabályozó szerepet tölthetnek be. Nincs olyan szerv, vagy olyan betegségtípus, amit ne lehetne valamilyen szinten összekapcsolni a bélflóra működésével. Az általa termelt anyagok a bélnyálkahártya immunrendszerét, immunműködését közvetlenül tudják befolyásolni, a bélben lévő immunsejtek a keringés révén más szervekhez is eljutnak, és ezáltal ott is kiválthatnak immunológiai választ.”
Maga a mikrobiom-kutatás egyébként nagyon aktív a tudományos világban, és az elmúlt néhány évben jelentős áttörések is születtek a bélflórával kapcsolatban. Michael Snyder, a Stanford Egyetemen működő, mikrobiom-kutatást is végző Snyder Laboratórium vezetője szerint a legfontosabbak ezek közül a bél–agy tengely felfedezése; a felismerés, hogy a mikrobiomunk nagy része életünk első három évében alakul ki; illetve hogy kiderült, hogy a nyugati kultúrákban élők a bélflórájuk harmadát az őseiktől örökölték; és persze az, hogy mindannyiunknak saját, egyedi mikrobiomja van, ami meglehetősen stabil.
Azt, hogy egy ember mikrobiomja mennyire egyedi, jól illusztrálják azok az ikreken végzett vizsgálatok, amik kimutatták: bár a bélflóra jelentős része öröklődik, a környezeti hatások miatt még az egypetéjű ikrek mikrobiomja is erősen különböző. Ilyen környezeti hatás lehet a légszennyezés, az étrend, a stressz, az alkoholfogyasztás és a dohányzás, sok más egyéb faktor mellett.
Éppen ezért olyan nehéz meghatározni az úgynevezett „törzsmikrobiomot”, vagyis azt az alapvető mikrobaközösséget, ami minden ember szervezetében megtalálható. Egyes kutatások szerint nem is lehet ezt önmagában leírni, és a fogalmat a környezet összefüggésében kell értelmezni – ideértve a test különböző részeit, a táplálkozást, de még a földrajzi elhelyezkedést is. Valószínűleg a bélflóra összetétele önmagában nem is alkalmas az egészséges mikrobiom előrejelzésére, mivel az emberekben – és akár még egyetlen emberen belül is – nagy eltérések figyelhetők meg a mikrobiomban a földrajzi helyzettől és az időtől függően is.
„Általános szabályként elmondható, hogy az egészséges mikrobiom meglehetősen változatos, sok fajból áll, és általánosságban a Bifidobacterium és a Lactobacillus törzsek egészségesek benne, mivel ezek rövid szénláncú zsírsavakat termelnek, amelyeknek számos pozitív hatása van a bélrendszer és az immunrendszer egészségére” – írta a Telexnek Michael Snyder. De mivel nincs pontos modell arra, hogy milyen az egészséges mikrobiom, azt is nehéz megállapítani, hogy milyen az, amikor diszbiózis jelentkezik, vagyis felborul a bélflóra állapota. „A diszbiózis egyik jellemzője a mikrobiális sokféleség csökkenése, a potenciálisan patogén baktériumok nagy száma és az említett hasznos mikrobák elvesztése” – mondta erről a szakértő.
„A mikrobiom különböző vizsgálatainál általában a bélösszetételt vizsgálják, és ebből próbálnak különböző következtetéseket levonni a beteggel kapcsolatban. Sokkal kevesebb az olyan vizsgálat, ami a bél által termelt metabolitokat vizsgálja, pedig azt gondoljuk, hogy igazából ezek hiánya, vagy ezeknek a változása az, ami befolyásolhatja egy betegség kialakulását. Ezért nagyon sok kérdés merül fel azzal kapcsolatban, hogy azok a vizsgálatok, amik a bélflóra kapcsán mostanában zajlanak, mennyire segítik a betegellátást, illetve mennyire pontosan tudják megmondani azt, hogy igazából mi a probléma” – vázolta a problémát Molnár Tamás. Kutatások kimutatták, hogy az emberek közötti eltérés sokkal nagyobb a mikrobiom fajösszetételében, mint annak funkcionális működésében, vagyis a metabolitok jelenlétében. Úgy tűnik ugyanis, hogy többféle baktériumfaj is képes ugyanazokat a funkciókat ellátni a szervezetben, ezért egyik megléte vagy hiánya nem feltétlenül jelenti azt, hogy a funkciója is elvész. Távoli hasonlattal élve: egy lakásban is többféle módon lehet megoldva a fűtés, és ha például nincs bevezetve a gáz, az nem jelenti azt, hogy emiatt biztosan fűtetlen a lakás. Nem az a fontos tehát, hogy a bélmikrobiomnak mik a tagjai, hanem inkább az, hogy mit csinálnak.
„Ne felejtsük el, hogy magát a baktérium-összetételt is különböző módszerekkel lehet vizsgálni, amik különböző mélységekben tudnak genetikai elemzéseket végezni. Ezek a vizsgálatok általában nem mélyrehatók, nagy általánosságban különböző DNS-szekvenciákat felszínesen hasonlítanak össze. Az összetétel meghatározása függ a vizsgáló technikától, és nem feltétlenül száz százalékban pontos. Azt sem nézik a legtöbb helyen, hogy a baktériumokkal együtt élő gombák és vírusok milyen szinten vannak jelen, azokban van-e változás. A kölcsönhatást, amit egymásra kifejtenek, nem vizsgálják” – mondta a szakértő.
„Az összetételről nagy általánosságban tudunk dolgokat, meg tudjuk mondani, hogy az általunk elvárthoz képest a baktériumok mennyisége és változatossága milyen, és azt, hogy bizonyos sztenderdekhez képest hogy néz ki. De összességében, ha bármilyen tudományos közleményben megnézzük, mi az a normál bélflóra, senki nem tudja definiálni, ez még egy adott populáción belül is borzasztóan változékony” – tette hozzá.
Alapvetően elmondható tehát, hogy minél sokszínűbb a bélflóra, annál jobban működik, és a sokszínűséget alapvető életmódbeli tényezőkkel lehet befolyásolni: a feldolgozott élelmiszerektől minél inkább mentes, rostdús táplálkozással, a rendszeres mozgással, a stresszcsökkentéssel, a dohányzás elhagyásával és az alkoholfogyasztás minimalizálásával vagy teljes megszüntetésével, illetve azzal, ha olyan helyre költözik az ember, ahol nem magas a légszennyezés. Ennél részletesebben azonban nehéz meghatározni, hogy kinek mitől „regenerálódik” a bélflórája, az olyan tesztek, amik egy-egy specifikus étel elhagyását vagy bevezetését javasolják ehhez, leginkább vaktában lövöldöznek, hiszen nem tart még ott a tudomány, hogy ennyire személyre szabott ajánlásokat lehessen tenni.
A mikrobiomteszteknek úgy lenne értelmük, ha nem egy pillanatnyi helyzetet vizsgálnának, hanem azt, hogy valakinek hosszú távon, évek alatt, esetleg egy betegség előtt, egészségesen, majd betegség közben és után hogyan változik a mikrobiomja. „Ez egy kicsit olyan, mint az ujjlenyomat. Mindenkinek más a bélflórája, viszont amikor egyetlen bélflóra-analízisből olyan következtetéseket próbálnak levonni, amit hosszú oldalakon keresztül részleteznek, akkor ezt gyakorlatilag úgy teszik, hogy nem tudják, az illetőnek milyen volt a bélflórája korábban, akár a panaszai kezdete előtt. Ha utánkövetés és többszöri bélflóra-elemzés születne, sokkal közelebb lennénk ahhoz, hogy mi változott meg az illető mikrobiomjában, ami esetleg a panaszokkal társul. Így saját magával tudnánk összehasonlítani, ez sokkal informatívabb lenne” – mondta Molnár Tamás.
Az egészen biztos, hogy a változó életkörülményeink befolyásolják a bélflóra állapotát, egyéni és társadalmi szinten is. A feldolgozott élelmiszerek elterjedése, a stressz, a légszennyezés, a mozgásszegény életmód, a klímaváltozás biztosan nem tesz jót a mikrobiomunknak, a túlzott antibiotikumhasználat pedig bizonyítottan káros az állapotára. Egyes tanulmányok szerint az elmúlt 80 évben az antibiotikumok elterjedése a bélmikrobák többgenerációs csökkenését okozta. Molnár Tamás viszont azt mondja, nem érdemes egyetlen tényezőre szűkíteni a változás okát. „Azt, hogy az antibiotikum az oka mindennek, erősnek tartom, de azt szerintem jogosan mondhatjuk, hogy azok az életkörülmények, amikben élünk, nagyon sok szempontból egyre aggasztóbbak, és biztosan negatívan befolyásolják a bélflórát.”
Nem lehet kijelenteni, hogy a rossz mikrobiom rákot okoz
De mi a helyzet a mikrobiom és a betegségek kapcsolatával? Michael Snyder szerint nagyon aktív kutatómunka folyik ezen a területen. „Különösen a mikrobiom és a betegségek közötti összefüggések terén aktív a szakma. Az egyik kiemelt érdeklődésre számot tartó terület a bél–agy tengely, mivel úgy gondolják, hogy a mikrobiom számos neurológiai állapotot, például a Parkinson-kórt és az autizmust is befolyásolja. Új kezdeményezés indult az emberi szervezetben található összes vírus tanulmányozására is” – írta a Telexnek.
A rendelkezésre álló tudományos vizsgálatok leginkább biomarkerként tekintenek a mikrobiomban megtalálható vagy éppen onnan hiányzó baktériumokra. Egyértelmű ok-okozati összefüggést eddig nem sikerült kimutatni, és a kísérletek nagy része is állatokon zajlott. Ez nem feltétlenül probléma, hiszen az egérkísérletek például nagyon hatékony első lépésként szolgálnak a betegségek megértéséhez, de szükséges melléjük olyan, embereken végzett kísérlet is, ami alátámasztja az állatkísérletek eredményeit. Michael Snyder is azt erősítette meg, hogy jelenleg a legtöbb, betegség és mikrobiom közötti kapcsolat inkább korreláció, de egereken végzett kísérletek mutatnak ok-okozati összefüggést is a mikrobiom változása és az elhízás, különböző fekélyek és bizonyos rákos megbetegedések esetén.
„A legtöbb kutatásban egy bizonyos betegség jelenlétekor vizsgálják a mikrobiomot, de így azt megmondani, hogy a felfedezett eltérés vezetett-e a betegséghez, vagy annak a következménye, nagyon nehéz, sőt valójában lehetetlen. Sokszor a daganatok és a gyulladásos bélbetegségek esetén vizsgálják a bélflórát. Utóbbival kapcsolatban az a helyzet, hogy mivel a mikrobiom hatással van az immunfolyamatokra, egyre inkább az az elképzelés, hogy olyan tényezők, amik a mikrobiom fejlődését már egy korai életkorban befolyásolják – például a császármetszéses születés, az antibiotikumok szedése gyerekkorban –, a korai immunfejlődésre is hatással lehetnek, és ez egy olyan tényező, ami az egyébként genetikailag hajlamos illetőben később ilyen bélbetegséget kialakíthat – mondta Molnár Tamás. – Az olyan állapotoknál, mint a bélgyulladás, a mikrobiom szerepe sokkal inkább tetten érhető.”
A daganatos megbetegedésekkel kapcsolatban sokkal több a kérdés, mint a válasz, ok-okozati összefüggést itt sem sikerült találni, és még ott sem egyértelmű a tudomány, ahol a legtöbbször sejtenek összefüggést a mikrobiom és a rák között: a potenciálisan a mikrobiom által is kiváltott gyulladásos bélbetegségek ugyanis csak az egyik oka lehet a vastagbélrák kialakulásának. Az Amerikai Klinikai Onkológiai Társaság szerint kutatják még a bélflóra és a rák kapcsolatát a kezelések sikerességének előjelzésében is. Kimutatták, hogy a bélmikrobiom jellemzői, beleértve a specifikus fajokat és a mikrobiom sokféleségét és funkcionalitását, befolyásolják a rákterápiák eredményeit és toxicitását, valamint a terápiák mellékhatásait. Azt is megjegyzik viszont, hogy ezeket a kutatási eredményeket nagyon nehéz megismételni és egyértelműen bizonyítani.
„Egy betegség kialakulásához nagyon sok tényező kell. Vegyük például a tüdőrákot, ahol a mikrobiom eltérésén túl egyértelműen kellenek a környezeti tényezők, például a dohányzás, a légszennyezés, és a genetika is, vagy hogy milyen gyógyszereket szedett az illető, milyen egyéb problémája van, és persze hogy milyen idős, az életciklusának milyen fázisában van. Ha ezt mind együtt nézzük, akkor azt kell hogy mondjuk, hogy a mikrobiom fontos része az egésznek, de nem önálló kóroki tényező” – mondta Molnár Tamás.
A krónikus betegségek számának növekedését is összefüggésbe szokták hozni a megváltozott bélmikrobiommal, amit pedig a megváltozott életkörülményeinkre vezetnek vissza. Itt azonban felmerül az a kérdés is, amit manapság a mentális betegségekkel és fejlődési rendellenességekkel kapcsolatban emlegetnek a leggyakrabban: valóban drámaian megnőtt ezeknek a betegségeknek az előfordulása, vagy csak egyre hatékonyabban tudjuk felismerni őket? „Ezeket a betegségeket 20 évvel ezelőtt nem akartuk összefüggésbe hozni a bélflórával, teljesen másképp magyaráztuk a szerepüket. Az, hogy most sok mindent a mikrobiommal próbálunk magyarázni, lehet annak a következménye, hogy valóban károsodott populációs szinten a bélflóra, de annak is, hogy olyan genetikai vizsgálómódszerek vannak a kezünkben, amelyek korábban nem voltak” – mondta Molnár Tamás.
Felmerülhet a kérdés persze, hogy ha a mikrobiomnak ekkora szerepe lehet, miért nem szed mindenki „jó” baktériumokat tartalmazó pro- és prebiotikumokat, hogy biztosra menjen. Itthon antibiotikumkúra során rutinszerűen ajánlja az orvos a probiotikumot a gyógyszer mellé, és vannak olyan klinikai esetek, amikor segíthet a kezelésben az ilyen étrend-kiegészítő, de összevissza szedni több okból sem érdemes. Egyrészt a pro- és prebiotikumok piaca szabályozatlan, hasonlóan a vitaminokéhoz, és nehéz megmondani, hogy valóban az, és akkora mennyiségben van-e bennük, amit a címkék állítanak. Másrészt, pontosan azért, mert nem ismerjük az egészséges mikrobiom összetételét, nem is tudjuk megmondani, hogy kinek milyen baktériumtörzseket kéne bevinnie a szervezetébe.
„Nagyon nehéz megállapítani, hogy egy adott ember állapotában milyen típusú probiotikum az, ami segíthet. Nem ismerjük az illető bélflóráját, de ha még ismerjük is, akkor sem vagyunk sokkal könnyebb helyzetben. Jelenleg még nem tartunk a személyre szabott probiotikus kezelésnél, így a hatékonyság sokszor nem kielégítő – mondta Molnár Tamás. – De egyértelműen látható az is, hogy ha valakinek puffadásos panaszai vannak, és javaslunk számára egy ilyen szempontból hatékony diétát, és probiotikumot adunk mellé, az képes kedvező irányba elindítani a dolgokat. Tehát meg kell találni az egyensúlyt a probiotikumok alkalmazásával és hatékonyságával kapcsolatban. Az biztos, hogy ha a szomszéd azt mondja, hogy az egyik probiotikum bevált neki, az egyáltalán nem biztos, hogy nekünk is be fog. Az a készítmény, ami többféle törzset tartalmaz, sem mindig jobb – előfordul, hogy az a hatékonyabb, ami egy törzset tartalmaz nagyobb mennyiségben.”
A mikrobiom-alapú gyógyításra még várni kell
„Elterjedt tévhit, hogy a mikrobiomnak van egy mindenkire érvényes, ideális állapota – mondta a Telexnek Soltész Erzsébet dietetikus. – A mikrobióta a lakóközösség névsora, a mikrobiom kifejezésbe a mikroszkopikus lakótársaink genetikailag kódolt képességeit, azok aktív kifejeződését és a belső környezetüket is beleértjük. A mikrobiótát a több száz baktériumfaj mellett több ezer féle vírus, gomba, archaea, állati egysejtű alkotja, de mind a szakirodalom, mind a közösségi média legtöbbször csak a baktériumokról beszél. Pedig a belső világunk jelentősége, működése csak a különféle mikrobák közötti viszonyrendszeren keresztül értelmezhető: például a mikrobiom önszabályozási képességének főszereplői azok a vírusok – az úgynevezett bakteriofágok –, amelyek a baktériumok elpusztításával tartják fenn a létszámegyensúlyt. A mikrobiom még jórészt feltáratlan belső viszonyrendszere és a testünk működésével való folyamatos kölcsönhatása együtt adhat magyarázatot az egyes betegségek kialakulásában játszott valós szerepére. A mikrobiomtudomány még csak néhány évtizedes, egyelőre a mikrobiom megismerésénél tartunk, a célzott, előre szándékolt irányú változtatására, a mikrobiom-alapú gyógyítás elterjedésére még várni kell.
Nem létezik egyelőre egyénre szabott táplálkozásterápia sem a mikrobiom befolyásolására. Nincsenek olyan szabályok, hogy ha például egy általában kedvezőnek tartott baktérium aránya alacsony valakinél, akkor holnaptól ne egyen húst, vagy hogy egyen sok áfonyát és zabpelyhet, és akkor az garantáltan visszabillenti az arányokat. Ez nem is lehet önmagában a mikrobiom-támogatás célja, hisz ez nem egy kétpólusú világ, nincsenek mindig jó és mindig rossz mikrobák.”
A dietetikus ugyanakkor megjegyezte, hogy vannak olyan táplálkozási és életmódbeli tényezők, amik már bizonyítottan összefüggésbe hozhatók a mikrobiommal. „Ami biztosan befolyásolja a benne zajló folyamatokat és a szervezetünkkel való kölcsönhatását, az az étrendünk, a mozgás mennyisége, a gyógyszerszedés. Az antibiotikumok esetenként igazi tömegpusztítást végeznek, de más gyógyszerek, így például a gyomorsavtermelésre ható protonpumpagátlók is hatással vannak rá. Az alváshiány, a stressz, a dohányzás, az alkoholfogyasztás, a túlzott tisztaság, az élelmiszereinkben lévő adalékanyagok és a háztartási kemikáliák is veszélyeztetik a mikrobiom egyensúlyi állapotát. Sőt, amit ritkán emlegetnek, az a hiányzó kapcsolódás a globális mikrobiom sokszínű világával: épp ezért legyünk kint sokat a természetben, jó levegőn, érintkezzünk a talajjal, a növényekkel, háziállatokkal, és találkozzunk más emberekkel.”
Persze ezt városi környezetben egyre nehezebb megtenni, de azt érdemes észben tartani, hogy a mikrobiomunk nem elszigetelt világ: dinamikusan reagál és változik a környezeti hatásoknak megfelelően, és azokra adott válaszul. A kívülről érkező negatív hatások egy részét alig tudjuk befolyásolni: a mezőgazdaságban használt szereket már szinte lehetetlen elkerülni, a mikroműanyagok egyre több helyen felbukkannak, és a mindennapi életünk része lett a folyamatos stresszt jelentő információs túlterhelés is.
„Alapvetően a mikrobiom reziliens: a dinamikusan változó külső-belső környezeti hatásokra rugalmasan reagálva képes megőrizni az egyensúlyi működését. A gond az, hogy az evolúció nem készített fel a modern világ bennünket érő hatásaira – mondta a szakértő.
– Alapvetően már alig eszünk olyan élelmiszert, ami tényleg kapcsolatban volt a helyi környezetünk számunkra ismerős mikrobiomjával, emiatt is veszíthet sokszínűségéből és ellenálló képességéből a humán mikrobiom. Sok kutató ezt teszi meg a járványszerűen terjedő krónikus betegségek egyik fő okának.”
Az ideális valószínűleg az lenne, ha a saját mikrokörnyezetünkből származó élelmiszereket fogyasztanánk, de ezt persze nem teheti meg mindenki. Ezzel együtt, aki szeretne a mikrobiomjára vigyázni, fogyasszon minél többféle növényi élelmiszert, mindennap, változatosan. Bizonyítottan támogatják a mikrobiom egészségelőnyt adó működését, azaz prebiotikumok a zöldségekben, száraz hüvelyesekben, gyümölcsökben, teljes értékű gabonafélékben és magvakban található egyes élelmi rostok és az antioxidáns hatású polifenolok. A prebiotikumok legjobb forrása a sokszínű, elsősorban növényi alapú étrend, saját preferencia alapján kiegészítve az értékes makro- és mikrotápanyag-forrást jelentő, állati eredetű élelmiszerekkel. „A lokalitásra érdemes törekedni, például ha tehetjük, ne a Dél-Amerikából hozott Pink Lady almát együk, hanem a hazai fajtákat. A szezonalitás is sokat számít: a helyi idénytermények fenntarhatóbbá és egyben ismerősebbé teszik étrendünket a mikrobiomunk számára. A sokszínű, kevés feldolgozott élelmiszert tartalmazó táplálkozás melletti érv, hogy ezek az alapanyagok az eredeti formájukban, az úgynevezett »food matrix«-ban fejtik ki leginkább előnyös hatásukat. Nem mérhető össze ezzel egy diétás kenyérhez adagolt bambuszrost vagy cukros bolti kekszhez adott rostkivonat hatásossága. A jó minőségű rostkészítmények választékbővítésre, rohanós napokra alkalmasak, de ne pipáljuk ki a rostbevitelt reggelente pár rostkapszula bekapkodásával.”
Bár a fitonutriensek legkedvezőbben a természetes formához közeli növényi alapanyagokból hasznosulnak, találunk kivételt is. Soltész Erzsébet a paradicsomot hozza példaként: a likopin nevű antioxidánshoz a nyers paradicsomhoz képest a sűrített paradicsomszósz kedvezőbb forrás. „Az élelmi rostok az ételkészítés során nem vesznek el, jórészt bennmaradnak a kész ételben, de változhat a tápcsatornában kifejtett hatásuk. Egyes vízoldékony rostoknál csökkenhet az a fontos tulajdonság, hogy sűrű gélt képeznek a vékonybélben, így pont a számunkra előnyös, vércukorszint- és koleszterinszint-szabályozó hatásuk mérséklődhet” – mondta a dietetikus. Hozzátette, hogy nemcsak a klasszikus zöldségekben, hanem például a száraz hüvelyesekben, gyümölcsökben, magvakban és a gabonafélékben is vannak rostok, így a rostbevitel nem korlátozódik a zöldségekre. „Van egy sor hagyományos rostforrás élelmiszer, amit nem népszerűsítenek, pedig mindig is ott volt a bolti polcokon. A hajdina, a gersli, a száraz bab filléres tételek, csak persze a chia magnak jobb a marketingje.”
A prebiotikus rostok legjobb forrásai a növényi élelmiszerek. Ezeket a rosttípusokat a bélbaktériumok képesek felhasználni tápanyagként, és a fermentáció során a mikrobiom és a bél egészsége számára kulcsfontosságú zsírsavakat termelnek. „A prebiotikumnak számító rezisztens keményítő segítheti a jó zsírsavakat termelő baktériumok szaporodását. Tévhit, hogy csak a főzőbanánban vagy tápiókában található meg ez a rost, a főtt-visszahűlt burgonya, a rizs és a zabpehely is jó forrása. A többi prebiotikum, így az inulin, illetve a száraz hüvelyesek és gyümölcsök rostjai is támogatják a kedvező hatásúnak tekintett baktériumok térnyerését, a potenciális gyulladáskeltő mikrobák kiszorítását” – mondta Soltész Erzsébet.
A szakértő szerint a mérsékelt hús- és halfogyasztás is beilleszthető a kiegyensúlyozott étrendbe, de fontos, hogy a fehérjét lehetőleg ne feldolgozott termékek, adalékanyagokkal teli húskészítmények formájában vigyük be. „Az ultrafeldolgozott élelmiszerekben lévő tartósítószerek, emulgeálószerek, állományjavítók, az ízfokozó nátrium-glutamát rendszeres fogyasztás esetén a mikrobiom egyensúlyát is megzavarhatják. De alapvetően a túl sok telített zsír és a túlzott sóbevitel is fokozhatja a bélben a fehérjemaradékokat rothasztó, gyulladáskeltő vegyületeket termelő baktériumok tevékenységét. A genetikai hajlam és az életmód mellett az egyéni mikrobiom is befolyásolja, hogy ez valakinél milyen mértékben járul hozzá a bél és a máj gyulladásos állapotához vagy épp az emésztőrendszeri daganatos elváltozások kialakulásához. Mivel a mikrobiom alapesetben képes az önszabályozásra és a rugalmas alkalmazkodásra, nem kampánydiétára, hanem fenntartható, kiegyensúlyozott életmódra érdemes törekedni, ami nem válik öncéllá.”
A dietetikus szerint az időszakos böjt (időablakos étkezés), amit egyebek között a mikrobiom regenerálására is szoktak ajánlani, sokak számára működő táplálkozási minta lehet. Több kutatás megerősíti, hogy a némileg csökkentett energiabevitel és a napon belüli hosszabb étkezésmentes idő támogathatja az egészségmegőrzést. „Javulhat az inzulinérzékenység, beindulhat a fogyás, kedvezően változhat a koleszterinprofil – ezek a kedvező hatások magának a kalóriadeficitnek, a tudatosabb ételválasztásnak is köszönhetők. A napon belüli koplalás sok tudós szerint támogatja az autofágia beindulását: ilyenkor a szervezet megszabadul a selejtes sejtektől, sejtalkotóktól, azaz beindul egy öntisztuló-újrahasznosító rendszer, ami segíthet a krónikus betegségek elkerülésében, az egészséges élettartam meghosszabbításában. Az időszakos böjtöt saját döntés alapján ki lehet próbálni, de sokaknál – munkavégzés jellege, az életvitel vagy fennálló betegségek miatt – nem életszerű a rövid étkezési időablak. A mereven kezelt önkorlátozás akár hozzájárulhat a fennálló evészavarok, például az ortorexia súlyosbodásához.” Hormonálisegyensúly-hiány, például pajzsmirigy-alulműködés, menstruációs zavar, alultápláltság, közeljövőben tervezett várandósság esetén nem is javasolják a szakemberek az időszakos böjtöt.
Megzavarhatják a mikrobiom egyensúlyát az intenzív mesterséges édesítőszerek, így a szacharin, az aceszulfám-K, az aszpartám, a ciklamátok és a szukralóz is. „Friss kutatási eredmények alapján ezek hozzájárulhatnak a bélmikrobiomban a jobb energiakinyerést segítő baktériumok térnyeréséhez, így pont a hízás irányába hatnak. Egyelőre csak állatkísérletben, de már igazolták cukoranyagcserét rontó, potenciálisan gyulladásfokozó hatásukat. Az aszpartám ráadásul átjut a vér–agy gáton, és az agyban közvetve gátolja a dopamin és a szerotonin neurotranszmitterek előállítását, kémiai stresszfokozóként növelheti a szorongás és a depresszió kockázatát” – mondta a dietetikus. A vastagbélbe eljutó mesterséges édesítőszerek belepiszkálhatnak a mikrobiom önszabályozásához szükséges belső kommunikációs rendszerbe is.
„Ha az étrend gerincét olyan alapanyagok adják, amik az értékes beltartalmukat nagyrészt még hordozzák, az jó alap. A természetes összetevőkből kiinduló, otthoni ételkészítés reneszánsza örömteli, és segíthet, hogy csökkentsük az ultrafeldolgozott élelmiszerek fogyasztását. Ez különösen fontos a bélmikrobiom szempontjából, hiszen egyre újabb kutatások igazolják a túlzott mértékben bevitt adalékanyagok negatív hatásait. A mikrobiomot támogató étrend leginkább a mediterrán diétának nevezett táplálkozási mintára, illetve a dietetikusok által ajánlott flexitáriánus étrendre hajaz. Külön hangsúlyt érdemelnek a rostok: tudatosan törekedjünk a rostforrások változatos bevitelére, és mellette a probiotikus hatású élelmiszerek rendszeres fogyasztására” – tette hozzá Soltész Erzsébet.
Az mindenképpen igaz, hogy a mikrobiom-kutatásban óriási lehetőségek rejlenek, de az egyelőre nem tiszta, hogy pontosan mekkora jelentősége is lesz az „egészséges mikrobiomnak” a betegségek gyógyításában vagy megelőzésében. Az első lépés a megfelelő hasznosításhoz az, hogy létezzen egy módszer, ami klinikailag is releváns, olcsó, meg lehet határozni vele a mikrobiom pontos összetételét és azt a sztenderdet, ami általánosan egészségesnek mondható. „A legfontosabb az, hogy minden vizsgáló módszer akkor hasznos és előnyös, ha olyan konzekvenciákat lehet belőle levonni, ami gyakorlati haszonnal jár az illető részére. Jelen pillanatban én azt gondolom, nem tartunk még ott, hogy ezek a vizsgálatok a napi rutin részeként számottevő előnnyel járnak az illető egészségére. De elképzelhető, és remélem is, hogy hamarosan el fogunk jutni idáig” – mondta Molnár Tamás.
Ha többet tudunk a mikrobiomról, akkor célzottan képesek lehetünk befolyásolni annak a szervrendszernek megfelelően, amiről most azt gondoljuk, hogy biztosan kapcsolatban van vele. Ez rengeteg területet érint: a depressziótól a demencián át a daganatokig, a gyulladásos kórképekig és az epilepsziáig szinte mindennel kapcsolatban felmerül, hogy a mikrobiom szerepet játszhat benne. Az, hogy valójában mekkora segítség lesz végül a gyógyításban és a megelőzésben, még kérdés – lehet, hogy óriási, de az is lehet, hogy ma még jócskán túlbecsüljük a jelentőségét.